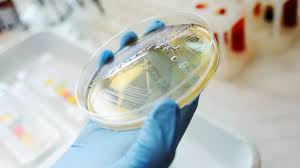

- Détails
- Affichages : 2082
D’après le dernier numéro du Journal Officiel de la République Tunisienne (Jort) du 19 avril 2024, le professeur Samia Menif Marrakchi a été nommée directrice générale de l’Institut Pasteur de Tunis (IPT).

Biographie de Pr. Samia Menif
Samia Menif est professeure de médecine à la faculté de médecine de Tunis, et cheffe de service du laboratoire d’hématologie à l’Institut Pasteur de Tunis depuis 2013. Spécialiste en Hematologie Biologie, elle a mis en place pour la première fois en Tunisie et dans la région du Maghreb, le diagnostic moléculaire des leucémies depuis 2003. Cette activité draine des patients de tout le territoire national.
Elle a été membre du conseil d’administration de l’institut Pasteur de Tunis de 2013 à 2016 et membre du conseil scientifique de l’institut pasteur de Tunis de 2015 à 2018.
Elle est affiliée au laboratoire de recherche d’hématologie moléculaire et cellulaire (LR16IPT07) à l’Institut Pasteur de Tunis depuis 2005 ou elle supervise des activités de recherche dans le domaine des leucémies et la résistance aux inhibiteurs de tyrosine kinase. En 2017, elle devient cheffe du laboratoire. Depuis 2017 elle dirige le laboratoire de recherche d’hématologie moléculaire et cellulaire LR16IPT07.
La Professeure Samia MENIF succède au Professeur Hechmi LOUZIR, devenant ainsi la première femme à occuper le poste de Directrice Générale de l'Institut Pasteur depuis sa fondation en 1893.
Contact:
Email:
Tel: 216 71783 022 / 71 843 755 poste 101
- Détails
- Affichages : 2861
Le secteur « Diagnostic et Santé Publique » de l'Institut Pasteur de Tunis comporte:
- 18 laboratoires spécialisés et unités impliqués dans les activités de diagnostic biomédical et dans les programmes nationaux et internationaux de Santé publique.
- 33 cadres médicaux et juxtamédicaux biologistes, ayant une expertise solide et reconnue dans leurs domaines respectifs
- Détails
- Affichages : 3194
TDR Regional Training Centre (RTC) in Eastern Mediterranean Region (EMR)

The Regional Training Centre of Institut Pasteur de Tunis (IPT) focused mainly on the promotion of quality assurance and good practices (current Good Clinical Practices (GCP), Good Clinical Laboratory Practices (GCLP)) ethics and human protection in research in addition to the Implementation of Research to solve health problems using the TDR toolkit and the GHRP course.
MISSION/ VISION
Training is the mission of our RTC and one of the main tasks of IPT. This mission is facilitated by the location of the RTC at the Institut Pasteur of Tunis (IPT) which has a unique position as a Reference Health Research Center with a multidisciplinary training staff. The training mission of IPT includes management of clinical research training of undergraduate, MDs, MVDs, MSc, and PhD students and post-doctoral students, the interaction with the boards of the Université de Tunis El Manar and Doctoral schools at the ‘Faculté des Sciences’ and the ‘Faculté de Médecine’ in Tunis. It also includes the organization of training courses in a range of disciplines to benefit different profiles including health personnel and program managers of the primary health care direction.
The goal of the RTC strategy is:
i)To foster research on infectious diseases of poverty that lead to health improvement;
ii)To strengthen research capacity of the individuals and institutions in countries of the region;
iii) To foster implementation research that responds to health needs of these countries through a range of training courses and activities.


- Détails
- Affichages : 6107
|
Liste des projets Internationaux |
||
| Code | PI | Titre |
| IMM110 | ALIA BENKAHLA | H3ABionet :A Sustainable African Bioinformatics network For HAfrica |
| NIH-TB 1 | CHAOUKI BEN ABESSALEM | Dynamics of the cellular and molecular architecture of human pulmonary TB granulomas |
| NIH-TB 2 | CHAOUKI BEN ABESSALEM | Cellular and molecular architecture of granulomas in human tuberculous lymphadenitis |
| COBRA | BALKIS BOUHAOULA | Developing the next generation of anti-venoms to improve management of cobra poisonings in low and middle incoming countries acronyme COBRA-NGaV |
| EEP69 | EMNA HARIGA | Bioinformatics and artificiel inteligence for infectious and negleced diseases drug discovery research platform |
| UNIHEALTH | ALI BOUATTOUR | Development of a global diagnostic ecosystem for detecting and monitoring emergency-prone pathogens across species and in a unified way |
| PERMEDINA | Yosr Hamdi | PerMediNA-Consortium Nor-African de Médecine de précision -Tunisie, Algérie , Maroc |
| AMAX | Amira Kbair | Grand hallenges Strengthening Modeling -Tunisia:African Modeling and Analtytics Academy for Women |
| MYC09 | Sadri Znaidi | A Responsible Artificial Intelligence-driven Initiative for Tackling Waterborne Pathogen (re)Emergence in Tunisia (INTERACT) |
| VISION | Fatma Guerfali | From insightful Science to innovate Health Strengthening translational capacity and talent interoperablility in Vaccine and Biologic Research and biologic Research and innovation |
| LESV20 | Elyes Zhioua | The Ixodes ricinus group of ticks in the Central e+Europe and North Africa :new insights into population genetics and associated pathognes |
| LESV19 | Elyes ZHIOUA | Sutveillance of Arbovirus causing Acute Febrille Illness in Tunisia |
| LESV18 | Elyes ZHIOUA | Mosquitoes surveillance and detection of arbovirus and insecticide resistance in Tunisa |
| EEP51 | Dhafer Laouini | STRENGTHENING THE SURVEILLANCE AND CONTROL OF INFLUENZA PROGRAM IMPLEMENTED IN TUNISIA |
| EEP53 | Samir Boubaker | "A regional training center for research on infectious diseases of poverty with a focus on intervention and implementation research the WHO Eastern-Mediterranean region |
| TOX43 | Ines Elbini | Animal venom biomolecles in Parkinson's diease therapy |
| MYC08 | Sadri Znaidi | An Institut Pasteur International Network Initiative for tacking a global emergigng threat multidraug resisitant yeast candidas auris |
| IMM158 | Meriem Belghith | Améliorer la capacité de réponse des instituts de santé Africains face aux crises épidémiques |
| RAGE | Meriem Handous | Reversement contrat foran oie laboratory o(or collaborating center) twinning project t OIE JUMLAGE RAGE |
| PAR17 | Karim Aoun | Clinical and parasitological features of cutaneous leishmaniassis with treatment failure /apse in endemic foci of Algeria and Ttunisia focus on oxidative stree makers and immunue responge |
| IMM151 | Chiraz Atri | Etude Pré-clinique pour l'obtention de mise en marche d'un médicament biologique similaire contenetenant l'interféron β'-1 en Tunisie |
| IMM152 | Marwa Mannai | Discovering anti-tumor and anti-metastatic effect of “BIO-11006” a novel peptide that inhibits MARCKS protein, a potential biomarker of inflammatory breast cancer |
| SPOT | ALI BOUATTOUR | Harnessing Sequencing-based technomogies for pandemic preparedness using o one Health-based approch in Tunisia and neighboring countries |
| IMM150 | Hechmi Louzir | Development of mRNZ vaccine against cutaneous leishmaniais |
| CANLEISH | Fethi Diouani | The grant is awarded for the action entitled ‘Non-invasive volatiles test for canine leishmaniasis 1er tranche |
| VIR19 | Anissa Choukha | Hepatitis E virus infection in pregnant Women in Tunisia |
| EEP 71 | Ikram GUIZANI | African Leishmaniases Consrortium ALC : Developing a paradigm for eliminating neglected diseases in Africa |
| IMM 157 | Fatma Guerfali | Alliance pour l'extension de la surveillance de pathogène dans les eaux usées ATLANTIS |
| AGDH | Kais Ghedira | African Genomic Data Hub |
| VIMC | Slimen Ben Miled | Vaccine impact Modelling Consortium |
|
Liste des projets Nationaux |
||
| Code | PI | Titre |
| IMM154 | Chyrine Charfeddine | Intérêt et Apport du séquençage d'exome dans le diagnostic de la surdité en Tunisie : De la recherche vers la pratique médicale en santé Auditive ISSMA |
| PAR15 | Aida Bouratbin | Agreement for co-operation between the university of naples Fedirico TT and IPT |
| CNVZ | Abderrazek Maaroufi | Etude étiologique sur les maladies aboratives chez les petits ruminants |
| OMICS | Sinda Zarrouk | CIC Microbiote de l'organisme humain et santé |
| MMVDB | HELMI MARDASSI | LABO MICROBIOLOGIE ,MOLECULAIRE, VACCINOLOGIE ,DEVELOPPEMENT, BIOTECHNOLOGIE |
| HMC | Samia Menif | laboratoire Hématologie moléculaires et cellulaires |
| LTCII | RIDHA BARBOUCHE | Laboratoire de Recherche sur Transmission,Le Contrôle et L'immunobiologie Des Infections |
| LGBO | SONIA ABDELHAK | LABORATOIRE DE GENOMIQUE, BIOMEDICALES ET ONCOGENETIQUE |
| MEEP | IKRAM GUIZANI | LABORATOIRE D'EPIDEMIOLOGIE MOLECULAIRE ET PATHOLOGIE EXPERIMENTALE APPLIQUEE AUX MALADIES INFECTIEUSES |
| LEMV | Abderazk Maaroufi | Laboratoire D'épidémiologie et de Microbiologie Vétérinaire |
| BIMS | SLIMEN BEN MILED | Bioinformatique ,Biomathématique et Biosatistique |
| PMBB | AIDA BOURATBINE | Laboratoire de Parasitologie Médicale,Biotechnologie et Biomolécule |
| UVT | OUSSEMA BEN FADHEL | UNITE DE VALORISATION ET DE TRANSFERT TECHNOLOGIQUE |
| UNISS | HICHEM BEN HASSINE | UNITE DE COMMUNICATION SCIENCE ET SOCIETE |
| PMO | NAJET HADHRI | UNITE VEILLE MONTAGE ET ACCOMPAGNEMENT DES PROJETS |
| UPT | SINDA ZARROUK | UNITE SPECIALISEE PLATE FORME TECHNOLOGIQUE IPT-Omics |
| LBVAT | NAJET SRAIRI | Laboratoire des Biomolécules, des Venins et des Applications Théranostiques |
| LVVH | ALI BOUATTOUR | LABORATOIRE VIRUS VECTEURS ET HOTES ONE HEALTH |
| ARBO | YOUMNA MGHIRBI | Evaluation des risques liés à l'émergence des arbovirus dans deux pays voisins (Algérie et Tunisie): virus du Nil occidental, virus de la fièvre hémorragique de Crimée-Congo et virus de la fièvre de la vallée du Rift |
| PJC14 | Insaf Bel Haj Ali | "Vers la mise en place d'une valise pour duagnostic moléculaire de la Ovid-19 au pont de besoin |
| PJC15 | Houyem ouragini | Etude de l'implication de micro ARNs dans la thérapie des hémoglobinopathies |
| IMM149 | Rym KEFI | Etude multidisciplinaire des maladies mitochondrial |
| IMM155 | Rym Kefi | Identification de marqueurs génétiques pour le diagnostic précoce de la maladie d'Alzheimer chez des sujets tunisiens atteints de Diabète de Type 2 |
| EEP70 | Ikram Guizani | Approches multi-disciplinaires et cout-efficaces pour le reprofilage de molécules thérapeutiques contre les leisshmanioses |
| IMM154 | Chyrine Charfeddine | Intérêt et Apport du séquençage d'exome dans le diagnostic de la surdité en Tunisie : de la recherche vers la pratique médicale en santé Auditive ISSMA |
| IMM156 | Chiraz Atri | La Surveillance de AMR dans les eaux usées pour une meilleure approche One Health |
| IMM153 | Lilia Romdhane | Contribution à l’implémentation de la médecine de précision pour les maladies génétiques rares par des approches bio-informatiques et génomiques |
| PJC 16 | Marwa Mannai | Etude Pré-clinique de l'effet anti-métastique d'un nouvel inhibiteur de la protéine MARCKS, une cible thérapeutique potentielle du cancer du sein inflammatoire dans la population tunisienne |
| Tox45 | Najet Srairi | Biomolécules des venins:vers une rechrche translationnelle pour identifier et cibler des biomarqueurs de glioblastome( GBM ) chez la population Tunisiénne |
| Tox41 | Najet Srairi | Du venin aux molécules bioactives: Mécanisme d'action et thérapie ciblée anti cancéreuse ( PHC-UTIQUE) |
| DPT | Henda Triki | Maladies transmissibles: Histoire naturelle et outils innovants pour le diagnostic, la prévention et le traitement innovante |
| PAT04 | Yosr Hamdi | Caractérisation de la structure épidémiologique et génétique du cancer du sein en Afrique du Nord L'impact thérapeutique, social et économique |
| PCI34 | Awatef Bejaoui | Epidémiologie de l'infection brucellique chez les ruminants en Tunisie et évaluation durisque à l’interface Homme-animal |
| PCI35 | Wissem Ghawar | dentification of rodent reservoirs hosts of Leishmania killicki (syntropica) in Tunisia through a longitudinal study |
|
Liste des projets Financés par l'IPT |
||
| PCI36 | Rahma Ben Abderazek | Les bêta-lactamases de classe A responsables de la résistance aux antibiotiques dans les infections nosocomiales : banque combinatoire et sélection de Nanoanticorps spécifiques de la KPC-3 |
| PCI37 | Kais Ghedira | MetaCov2: Metagenomic and metatranscriptomic sequencing of COVID-19 patients for identification of SARS-CoV-2 co-infecting microorganisms potentially associated to Disease severity |
| PCI38 | Rym KEFI | Etude multidisciplinaire des formes monogéniques de diabère chez la population tunisienne |
| PCI39 | Insaf Bel Haj Ali | Specific detection of SARS CoV2Comparative evaluation of simple and rapid molecular tools for the sensitive and |
| PCI40 | Anissa Chouika | Development of a miniature electrochemical immunobiosensor for the serological diagnosis of the hepatitis A virus |